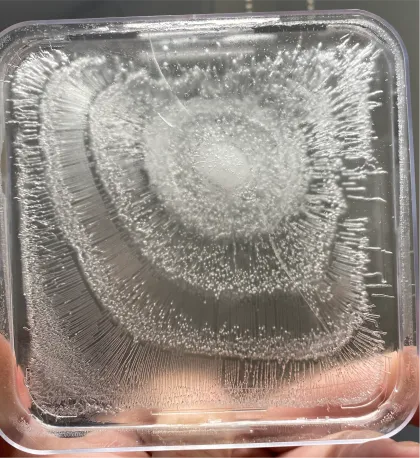

Water is life. It's the force that flows through everything, from nature to our own bodies. In every drop, there's an incredible energy and a hidden structure that fuels life's resilience.
Just like in nature, where the flow of water carves paths and creates ripples, the water we consume carries energy that can either nourish or drain us. That's why structured water is so essential, it's water in its most natural, vibrant state that is aligned with the very principles of life.
At Natural Action, we teach the science of structured, revitalized water and how water's structure affects everything from our hydration to the health of our planet. It's not just about hydration, it's about optimizing the state of water for better energy, health and vitality.
Water revitalization restores water's natural abilities, addressing issues that filtration alone cannot.
Proper water structuring deals directly with restoring the whole water and removes the toxic signature (identified by 90 degree crystal growth) resulting from modern methods of water handling. Filtration does not address this issue and can further add a degrading effect to the water.
Water revitalization not only deals with altering the degree of water but also alters the structure of the whole water body, its behavior, and influence on solutes in the water to make them more bio-available or bio-removable from any system.
Alone, or when combined with filtering, water can be returned to its natural state. Through simple and cost effective means, water revitalization technologies can render significant benefits wherever the water flows by bringing its natural function back to a higher degree of efficiency.
Filtering water focuses on treating less than 1% of total water, ignoring the rest. Crystal microscopy and spectroscopy show how pumping, chemicals and filtering degrade water. Learn more about this below.
Water Quality Basics
With a focus on water health, Natural Action strives to be the ultimate source for filtration and water structuring products.
Water Quality Terms
Explore a list of commonly used terms in the structured water community. Definitions include Functional Water, Structured Water, Hexagonal Water, and Charged Water. Discover the world of revitalized water!
Water Quality Summary
When it comes to everyday water use, natural structuring methods are preferred over electrical or magnetic processes in the long term. This involves utilizing flow vortices and subtle piezo electric effects of materials.
Learn About the Science
Video Education - What is Living Water?
What’s the difference between water that just satisfies thirst, versus water that actively imparts life?
We’ve all heard the term Water is Life. And there’s so much truth to that. But it’s almost more accurate to say that living water is life. However, most of the water we come into contact with is dormant water.
Crystallography: Repeatable Changes in Energy Trends

Filling the petri dish using water fed directly through the device from the kitchen tap.

Crystallography of tap water pre test.

Crystallography of tap water post test

Crystallography of tap water post melting and re-freezing.

Crystallography of tap water post melting and re-freezing for the second time.
Test Conclusion:
After using the Natural Action device, Veda Austin observed a major structural change in the tap water, from disordered to complex woven wave patterns. What is even more interesting is the longevity of the impact. Even after allowing the ice sample to melt and refreeze twice, it is evident that the water has been affected permanently or at least semi-permanently. This is not a common observation. Even if tap water has structurally improved from an influence it will usually begin to degrade after melting and refreezing.
Improvement in Sound Frequency Application

Untreated Tap Water
Untreated Tap water with sound frequency applied
Charge stratification and annular polarization weak
Treated Tap Water
Treated Tap water with same sound frequency applied
Charge stratification and annular polarization quality improved after Natural Action Portable unit treatment